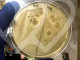

La instancia superior corrige a la jueza que archivó sin investigar y le advierte de que es "pertinente averiguar cómo, cuándo y por qué llegaron los datos de los periodistas" a Rodríguez y si la mano derecha de Ayuso los difundió para perjudicarles
Un juzgado rechaza imputar a Miguel Ángel Rodríguez por difundir datos de dos periodistas que investigaban a Ayuso
La Audiencia de Madrid ha aceptado el recurso presentado por el PSOE contra el archivo de las diligencias abiertas en un juzgado ordinario contra Miguel Ángel Rodríguez, jefe de gabinete de la presidenta madrileña, por haber difundido datos de dos periodistas de El País que elaboraban una información relacionada con Isabel Díaz Ayuso.
La titular del Juzgado de Instrucción número 25 de Madrid rechazó investigar a Rodríguez, en contra del criterio de la Fiscalía, y archivó la causa sin practicar diligencias. Ahora, la Sección Quinta de la Audiencia Provincial considera “pertinente averiguar cómo, cuándo y por qué llegaron los datos de los periodistas al querellado y si éste efectivamente difundió los mismos”.
En este sentido, la Audiencia Provincial de Madrid ordena a la jueza que practique “las diligencias que estime pertienentes” ante la posible comisión de un delito de revelación de secretos por parte de Miguel Ángel Rodríguez.
La magistrada entendió en su auto de archivo que los mensajes enviados por Rodrigúez a grupos de periodistas acusando falsamente a los profesionales de El País de acosar a vecinos de Ayuso no incurrieron en un delito de revelación de secretos al plasmar solo sus nombres y fotografía.
Miguel Ángel Rodríguez se implicó de lleno en la defensa de Alberto González Amador, pareja de Isabel Díaz Ayuso, después de que elDiario.es revelara que había sido denunciado por fraude fiscal. Rodríguez se dedicó durante esas semanas a atacar a los medios de comunicación que informaban sobre el caso.
El jefe de gabinete de Ayuso amenazó a elDiario.es difundiendo el bulo de que redactores de este periódico habían intentado entrar en casa de Ayuso encapuchados. De otro lado, aireó entre periodistas los nombres y fotos de dos reporteros de El País que buscaban información del caso en las inmediaciones del domicilio de la presidenta y su pareja. “Han estado acosando a los vecinos de la presidenta, incluido niñas menores de edad, en un acoso habitual en dictaduras”, afirmó.
El PSOE fue el primero en denunciar a Miguel Ángel Rodríguez por revelación de secretos, seguido de una querella presentada por el periódico y los dos periodistas. Todos acusaban a Rodríguez de haber expuesto de forma delictiva a los reporteros, añadiendo que había extraído esos datos de forma irregular de la Policía o alguno de los agentes que custodian la casa de la presidenta regional. La Fiscalía solicitó la apertura de una causa y que un periodista de El País testificara, además de aportar el mensaje de Rodríguez a la causa.
La respuesta del juzgado de instrucción 25 de Madrid fue rechazar la apertura de una causa contra el jefe de gabinete de Isabel Díaz Ayuso. “La simple referencia al nombre y primer apellido de dos profesionales en modo alguno puede estar comprendido en el concepto de secreto, dato o información reservada, pues ninguna afectación a la esfera privada de los periodistas ha tenido lugar con su sola identificación nominal”, argumentó la magistrada para avalar la actuación de Rodríguez.
Exponer a los dos reporteros ante otros periodistas acusándoles de acosar a niñas pequeñas, añadía la magistrada, tuvo “escasa o nula relevancia” en cuanto a su intimidad. Fue “su sola identificación, sin referencias añadidas a ámbitos íntimos, personales o confidenciales, al tratarse de un dato intrascendente”. El señalamiento de Rodríguez culminó con una foto de ambos periodistas, algo que tampoco es punible según esta magistrada al ser tomada “en la vía pública y en una actitud nada comprometedora ni para su esfera privada ni para el desarrollo de su intimidad”.

La presidenta explicará los detalles del pacto a partir de las 13h; la salida de Viciana de Educación, y la implicación de Presidencia, han resucitado unas negociaciones que estaban estancadas con el exconsejero
Ayuso intenta sofocar el incendio en la universidad con una subida del presupuesto tras años de recortes
Mini-punto para Díaz Ayuso. La Comunidad de Madrid ha alcanzado un acuerdo con los seis rectores de las universidades públicas de Madrid para poner en marcha un plan de financiación plurianual en los centros públicos. Con este pacto, que firmarán las partes esta mañana, la presidenta resuelve, al menos temporalmente, la crisis abierta en la región en los últimos meses a cuenta del estado económico de los campus, según ha avanzado ABC y confirmado este periódico.
La salida del Ejecutivo hace dos semanas del consejero de Educación, Emilio Viciana, y del grupo de los Pocholos, junto a la intervención de la Consejería de Presidencia –presente en la reunión ayer entre Comunidad y Cruma, la Conferencia de Rectores de Universidades Públicas de Madrid en la que se cerró el pacto– ha desatascado una negociación enquistada. Se espera que el Gobierno regional ofrezca los detalles del acuerdo a partir de las 13 horas, pero algunas fuentes especulaban la semana pasada con una subida gradual del presupuesto hasta alcanzar los 1.600 millones de euros dentro de cinco años, una cifra que a la presidenta de la Cruma y rectora de la Autónoma de Madrid (UAM), Amaya Mendikoetxea, le sonaba razonable, según explicó en una entrevista con Europa Press. Sería un aumento del 30% sobre los 1.239 millones actuales, aunque medido sobre el PIB supondría apenas pasar del 0,4% al 0,5%. La ley de universidades establece el 1% como meta.
Se le cierra (aparentemente) un frente a Ayuso, pero eso no quiere decir que vaya a acabar con la crisis en la universidad. A no ser que la presidente anuncie que va a duplicar el presupuesto, seguirá teniendo enfrente la oposición de las seis asambleas en defensa de las universidades públicas, que ya han anunciado que rechazan cualquier cifra de financiación que no se acerque a ese 1%. “Si nuestros rectores y gobernantes hacen anuncios oficiales que vayan en contra de los objetivos mínimos que tenemos, las Plataformas advertirnos que nos reuniremos de urgencia para organizar y convocar las movilizaciones, acciones y huelgas tan intensas como sea necesario hasta que se cumplan los mínimos señalados”, señalaron este lunes a través de una nota.
Y son las plataformas, no los rectores, quienes han liderado la protesta contra el Gobierno regional en los últimos meses. Son las plataformas las que convocaron una huelga que paralizó los campus el pasado mes de noviembre, punto de inflexión en las reivindicaciones que le acabaría costando el cargo a Viciana. Son las plataformas las que han mantenido viva la protesta, y no piensan parar, sostienen.
Pero la presidenta al menos dejará de oír quejarse a los rectores, que en el último año y medio han salido tres veces a protestar conjuntamente por la falta de financiación.
Las universidades necesitaban el acuerdo con urgencia. La situación de algunos centros, como la Complutense o la Rey Juan Carlos roza la desesperación. La primera ha tenido que pedir un crédito de 34 millones de euros para seguir funcionando, la segunda ha cerrado el pasado ejercicio con un déficit de 76 millones de euros.
Un camino diferente ha seguido la ley de universidades, el otro gran encargo que tenía Viciana, que la presidenta quería haber aprobado el pasado diciembre, pero que actualmente ni está ni se la espera. El texto tenía una gran influencia de Antonio Algarra Castillo, conocido como Rasputín en el Gobierno regional, un dramaturgo con gran ascendente sobre Viciana y sobre la propia Ayuso y líder del grupo de los Pocholos, hoy fuera de las estructuras de poder tras marcharse con Viciana. Pero los rectores habían rechazado de plano la propuesta de ley, que veían incorregible. Su apuesta iba por redactarla desde cero de nuevo, y la nueva consejera, Mercedes Zarzalejo, parece haber aceptado que es la única vía factible.

Una explotación histórica permite descender bajo el nivel del mar y recorrer galerías originales que conservaron la actividad minera durante más de tres siglos
La villa de Madrid con un palacete de inspiración neomudéjar y singulares vidrieras que está declarado Bien de Interés Cultural
En la costa central de Asturias, junto al mar Cantábrico, existe un acceso que conduce bajo tierra y bajo el nivel del mar. No es una recreación ni un espacio expositivo construido desde cero, sino una explotación histórica que forma parte del origen de la minería industrial en España. En el concejo de Castrillón, la Mina de Arnao conserva galerías excavadas hace casi dos siglos y un pozo vertical que marcó un punto de inflexión en la extracción de carbón en Asturias.
El enclave está considerado la explotación de carbón mineral más antigua documentada de la Península Ibérica. También es reconocido como el primer pozo vertical abierto en Asturias para este tipo de minería y como la única mina submarina desarrollada en Europa. Su trayectoria combina los primeros intentos de extracción en el siglo XVI con un desarrollo industrial consolidado en el siglo XIX y un cierre definitivo en el primer cuarto del siglo XX. La actividad se prolongó durante más de tres siglos, desde 1591 hasta 1915.
Tras permanecer inactiva durante décadas, la antigua explotación fue restaurada y convertida en museo. Desde 2013 está abierta al público con visitas guiadas que permiten descender al interior de las galerías originales. El castillete que protege el acceso al pozo fue declarado Bien de Interés Cultural en 2011, una figura que reconoce su valor histórico dentro del patrimonio industrial español.
La Mina de Arnao no solo es significativa por su infraestructura y antigüedad, sino también por el papel que tuvo en la vida social de la zona. La explotación generó un núcleo obrero alrededor del pozo y sus edificios auxiliares, configurando un pequeño conjunto habitacional vinculado a la actividad minera. Las familias de los trabajadores, la distribución de viviendas y la organización de servicios fueron elementos que acompañaron el desarrollo industrial y dejaron huella en la memoria histórica de la comunidad.
De los primeros hallazgos a la expansión bajo el mar
La referencia más antigua sobre la extracción de carbón en Arnao se sitúa en 1591, cuando Fray Agustín Montero informó al rey Felipe II del hallazgo de carbón en los acantilados de la zona y solicitó permiso para su aprovechamiento. Aquella experiencia fue breve, pero constituye la primera documentación conocida de una mina de carbón mineral en la Península Ibérica.
El verdadero impulso llegó en el siglo XIX. En 1833 se construyó el pozo vertical que hoy se considera el más antiguo de Asturias en la minería del carbón. Esta infraestructura permitió organizar la explotación de forma más profunda y sistemática. A partir de ese momento comenzaron a excavarse galerías que avanzaron bajo el lecho marino, una decisión técnica poco habitual en la Europa continental de la época.
La actividad estuvo vinculada a la Real Compañía Asturiana de Minas, que introdujo innovaciones en los métodos de extracción y consolidó el carácter industrial del enclave. Las labores llegaron a extenderse varios kilómetros y algunos niveles alcanzaron más de 200 metros bajo el mar. Durante la visita actual es posible descender alrededor de 20 metros hasta el primer piso de galerías, situado aproximadamente a la misma cota que el mar, mientras que los niveles inferiores permanecen anegados como consecuencia de las filtraciones.
En 1853 se levantó en Arnao una fundición de zinc para dar salida al carbón extraído, ante la dificultad de emplearlo en la siderurgia. Esa instalación convirtió a la comarca de Avilés en un punto de referencia en la producción de este metal durante el siglo XIX. La explotación no solo aportó mineral, sino que sirvió de modelo para formas de trabajo y soluciones técnicas que después se replicaron en otras cuencas asturianas.
Inundación, cierre y recuperación patrimonial
La cercanía del mar condicionó toda la vida útil de la explotación. Las entradas continuas de agua obligaban a mantener sistemas de bombeo constantes y encarecían el trabajo. A estas dificultades técnicas se sumaron episodios de conflictividad laboral. Finalmente, una gran inundación en 1915 precipitó el cierre definitivo de la mina.
Tras su clausura, las instalaciones quedaron abandonadas durante gran parte del siglo XX. El castillete de madera que cubre el pozo vertical se mantuvo como uno de los pocos elementos visibles en superficie. En 2011 fue declarado Bien de Interés Cultural con categoría de Monumento, lo que garantizó su protección legal y reconoció su relevancia dentro del patrimonio industrial asturiano.
La recuperación del conjunto comenzó en el siglo XXI por iniciativa del Ayuntamiento de Castrillón. Las actuaciones incluyeron la consolidación estructural de las galerías accesibles, la adaptación de los recorridos a las normativas de seguridad y la creación de un espacio expositivo en superficie. En 2013 la Mina de Arnao abrió sus puertas como museo, integrando el recorrido subterráneo y un centro de interpretación dedicado a explicar la evolución histórica del enclave y su papel en la industrialización regional.
En la actualidad, las visitas se realizan en grupos organizados y con guía. El itinerario permite recorrer tramos originales donde se conservan elementos constructivos del siglo XIX y observar cómo el agua ocupa los niveles más profundos, una imagen que resume las dificultades que llevaron al cierre. A escasos metros, la playa de Arnao y los acantilados completan el contexto geográfico de una explotación que nació condicionada por el mar y que desarrolló bajo él una infraestructura única en Europa.
La Mina de Arnao reúne así varios hitos en un mismo espacio: la primera explotación industrial de carbón en España, el pozo vertical más antiguo de Asturias y la única experiencia minera submarina documentada en el continente. Convertida en museo, permite recorrer un capítulo clave del inicio de la industrialización sin salir del litoral asturiano y entender cómo la geografía y la tecnología marcaron el desarrollo económico de la zona.

Las conversaciones entre las dos formaciones se han prolongado hasta poco antes de la sesión constitutiva de la XII Legislatura en la comunidad
PP y Vox, sin acuerdo en Extremadura y Aragón mientras se agudiza la crisis interna de la ultraderecha
Sin acuerdo. El PP y Vox han dado nuevos síntomas de las problemáticas negociaciones entre ambos partidos para garantizar la gobernabilidad en Aragón y han fracasado en su intento de pactar un candidato para la Presidencia de las Cortes de Aragón. Las conversaciones, que se han prolongado hasta el último suspiro, no han fructificado y los populares han dado su apoyo a la candidata designada por Jorge Azcón: María Navarro, que ha sido elegida con el respaldo únicamente de los diputados populares.
La sesión constitutiva de la Cámara, con la que arranca oficialmente la XII Legislatura en Aragón, ha llegado pues con sorpresa. Al final, pese a que se daba por hecho que habría acuerdo, no ha sido así. Incluso sonaban nombres en Vox para ser designados como segunda autoridad de Aragón. Pero nada. El PP ha respaldado a María Navarro, diputada ya la pasada legislatura –sonó como consejera–, muy próxima al presidente Jorge Azcón y exconcejal en el Ayuntamiento de Zaragoza.
En la primera votación, para la que se necesitaba mayoría absoluta, Navarro ha recibido el apoyo únicamente de los 26 diputados populares, mientras que al aspirante del PSOE –exportavoz y secretario provincial en Huesca Fernando Sabés– han ido 25, lo que unido a los 16 votos en blanco ha obligado a ir a una segunda votación para la que ya se requería solo mayoría simple. Ahí se ha repetido el resultado, lo que ha permitido proclamar para el cargo a María Navarro, diputada ya la pasada legislatura, muy próxima al presidente Jorge Azcón y exconcejal en el Ayuntamiento de Zaragoza.
La falta de acuerdo en las Cortes de Aragón llega con las conversaciones entre el PP y Vox aún en su arranque pese a haber transcurrido más de tres semanas desde el 8F, sin reuniones públicas y en un contexto político enrarecido ante la coincidencia con otros procesos electorales, ya concluidos –Extremadura– o futuros –Castilla y León–. Un cóctel que, unido a las interferencias provenientes de Madrid, complican mucho los contactos. De hecho, en la comunidad extremeña las relaciones entre los populares, liderados por María Guardiola, y la extrema derecha están rotas, algo que con probabilidad se visibilizará en la primera votación de la investidura, que el PP perderá con mucha probabilidad.

Más de medio siglo después de la inundación del río Arno, la Urna de Bottarone vuelve a tener sus colores originales
La reina que no quiso casarse: el peculiar caso de Isabel I de Inglaterra, la soberana que asistía a obras de Shakespeare
El 4 de noviembre de 1966, una terrible inundación asoló la ciudad de Florencia, provocando la muerte de 101 personas, dañando iglesias, bibliotecas y museos, y deteriorando millones de obras de arte. Entre ellas, se encontraba la Urna de Bottarone, obra maestra etrusca conservada en el Museo Arqueológico Nacional de Florencia.
Tallada entre el 425 y el 380 a. C., la obra quedó gravemente deteriorada por la combinación del agua contaminada y el barro, lo que obligó a someterla a una primera restauración. Esta tuvo lugar entre 1969 y 1970, fue dirigida por Francesco Nicosia y se limitó a la limpieza del barro que había llenado la pieza.
Pero con el tiempo, las superficies de la urna se volvieron grises progresivamente, haciendo que esta perdiera sus colores originales. En 2022, gracias a un acuerdo de financiación entre los gobiernos de Italia y Suiza, se puso en marcha una nueva campaña de estudio, diagnóstico y restauración de la pieza, que ha terminado ahora.
“La restauración ha devuelto el brillo y la intensidad a los colores originales de la urna, sacando a la luz el intenso abrazo de la pareja de esposos esculpida hace más de 2.400 años”, señala el diario italiano Finestre sull'Arte. La urna restaurada se presentó al público durante el evento de turismo y patrimonio cultural tourismA - Salone Archeologia e Turismo Culturale, celebrado en Florencia.

Una pareja en una urna funeraria
La urna, realizada en alabastro blanco con vetas grises, fue hallada en 1864 en la localidad de Bottarone, cerca de Città della Pieve, localidad de la provincia de Perugia. En aquel momento, pasó a formar parte colección de Giorgio Taccini, y más tarde llegó a la de Giuseppe Pacini. No fue hasta 1887 cuando la pieza entró en la colección de museos florentinos.
En muchos monumentos funerarios etruscos del siglo V a. C., el difunto suele ir acompañado de un demonio femenino alado que guía su alma al más allá. En esta urna, sin embargo, la figura femenina es la esposa, identificada por su gesto de desvelarse. Se trata de un elemento que hace que la obra sea iconográficamente excepcional.
“La urna de Bottarone fue un exitoso experimento de restauración con una colaboración a varios niveles de profesionales y recursos públicos y el uso de fondos internacionales. Una excelencia que devuelve un mensaje positivo para el futuro del patrimonio cultural que se nos ha confiado: de la catástrofe de la inundación a una nueva vida para la urna etrusca y para el museo”, declaró Daniele Federico Maras, director del Museo Arqueológico Nacional de Florencia, tras conocerse la noticia.